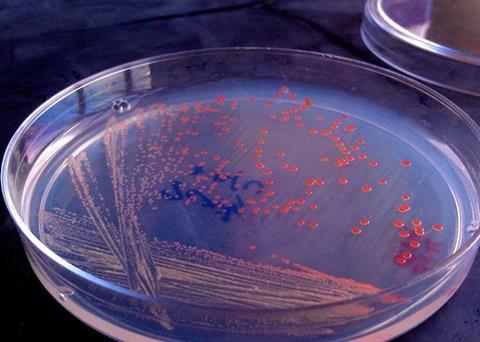
Advances in aquaculture will help meet the protein needs of a growing population Photo: KnipBio

Aquaculture feed producer, KnipBio, has completed a critical development step with the production of a single cell protein in a 20,000 litre fermentation vessel.
KnipBio Meal was developed in cooperation with a major North American contract manufacturer and is designed to demonstrate the scalability of the company’s manufacturing process ahead of commercial operations next year.
Larry Feinberg, chief executive of KnipBio, said that the team had worked tirelessly. “Successfully moving from 1,500-litre to 20,000-litre production is a critical pre-commercialisation step and offers solid proof that our fermentation process is highly scalable.”
“By working with a recognised leader in industrial fermentation, we were able to leverage their experience to overcome process challenges and at the same time identify improvements leading to significant manufacturing cost savings,” he added.
Meeting a growing population's needs
The aquaculture industry is well placed to meet the demands of a burgeoning population because fish are the most efficient source of animal protein, requiring a fraction of the land and fresh water needed to produce terrestrial protein.
According to experts, aquaculture has the potential to feed the planet using just 2 per cent of the ocean’s surface. To make this a reality, more proteins and oils are needed to feed farmed fish and shrimp as fishmeal is in increasingly short supply and concerns have been raised regarding soybean protein digestibility.
Research has shown KnipBio’s single cell protein closely resembles the amino acid profile of fishmeal and can also be a source of valuable immunonutrients, making it a promising alternative.